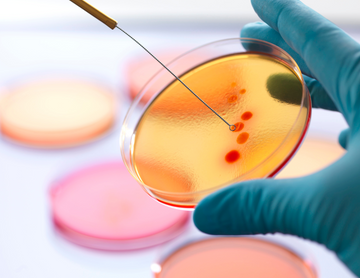

Uncommon Beauty Ingredients that are Great for Skin
Shea butter, honey, oats, and flower extracts are some of the most common ingredients you will see on the back of a skincare product label. These are widely used wonders that are infused into mass skincare products. But, as we transition into a world that is more aware of the magical benefits of the gentle infusion of science and nature, we are seeing new skincare ingredients that have never been heard of before, too. Here are some of them!

Colloidal Silver: This rare ingredient has been tried and tested by our ancestors as a healing earth element. This one proves miraculous in killing the bacteria on your skin while also protecting it against the same. Moreover, it offers a soothing effect on the skin.
Seaweed Algae: Extracted from sea plants, this unique ingredient comes with astonishing anti-ageing benefits that also come to your acne’s rescue. Bonus points for also serving as a deep cleanser for your skin!
Vitamin F: A power-packed combo of these two fatty acids, omega-3 and omega-4, Vitamin F is high in antioxidants. This wonder ingredient in any skincare product helps regulate and promote healthy functioning of the skin.
Aquaxyl: A new-age ingredient, which is also known as the ‘Father of Hydration,’ this helps offer your skin deep hydration, while also infusing it with the essential protein and collagen that is essential for our skin’s health.
D- Panthenol: Known as a strong skin protectant, D-panthenol comes packed with anti-inflammatory properties that also help improve skin elasticity and hydration, giving it speckless smoothness.
Apple cider: Enriched with AHA, this natural vinegar is a proven remedy when it comes to removing dead skin, and fading the appearance of fine lines, age spots, and wrinkles.
While these skincare superstars aren’t as common as the mass-used ones, they have still proven to lend such transformative and game-changing benefits that they are slowly changing the whole dynamic of the skincare industry. So, are you ready to embrace this transition with skincare packed with these rare treasures?